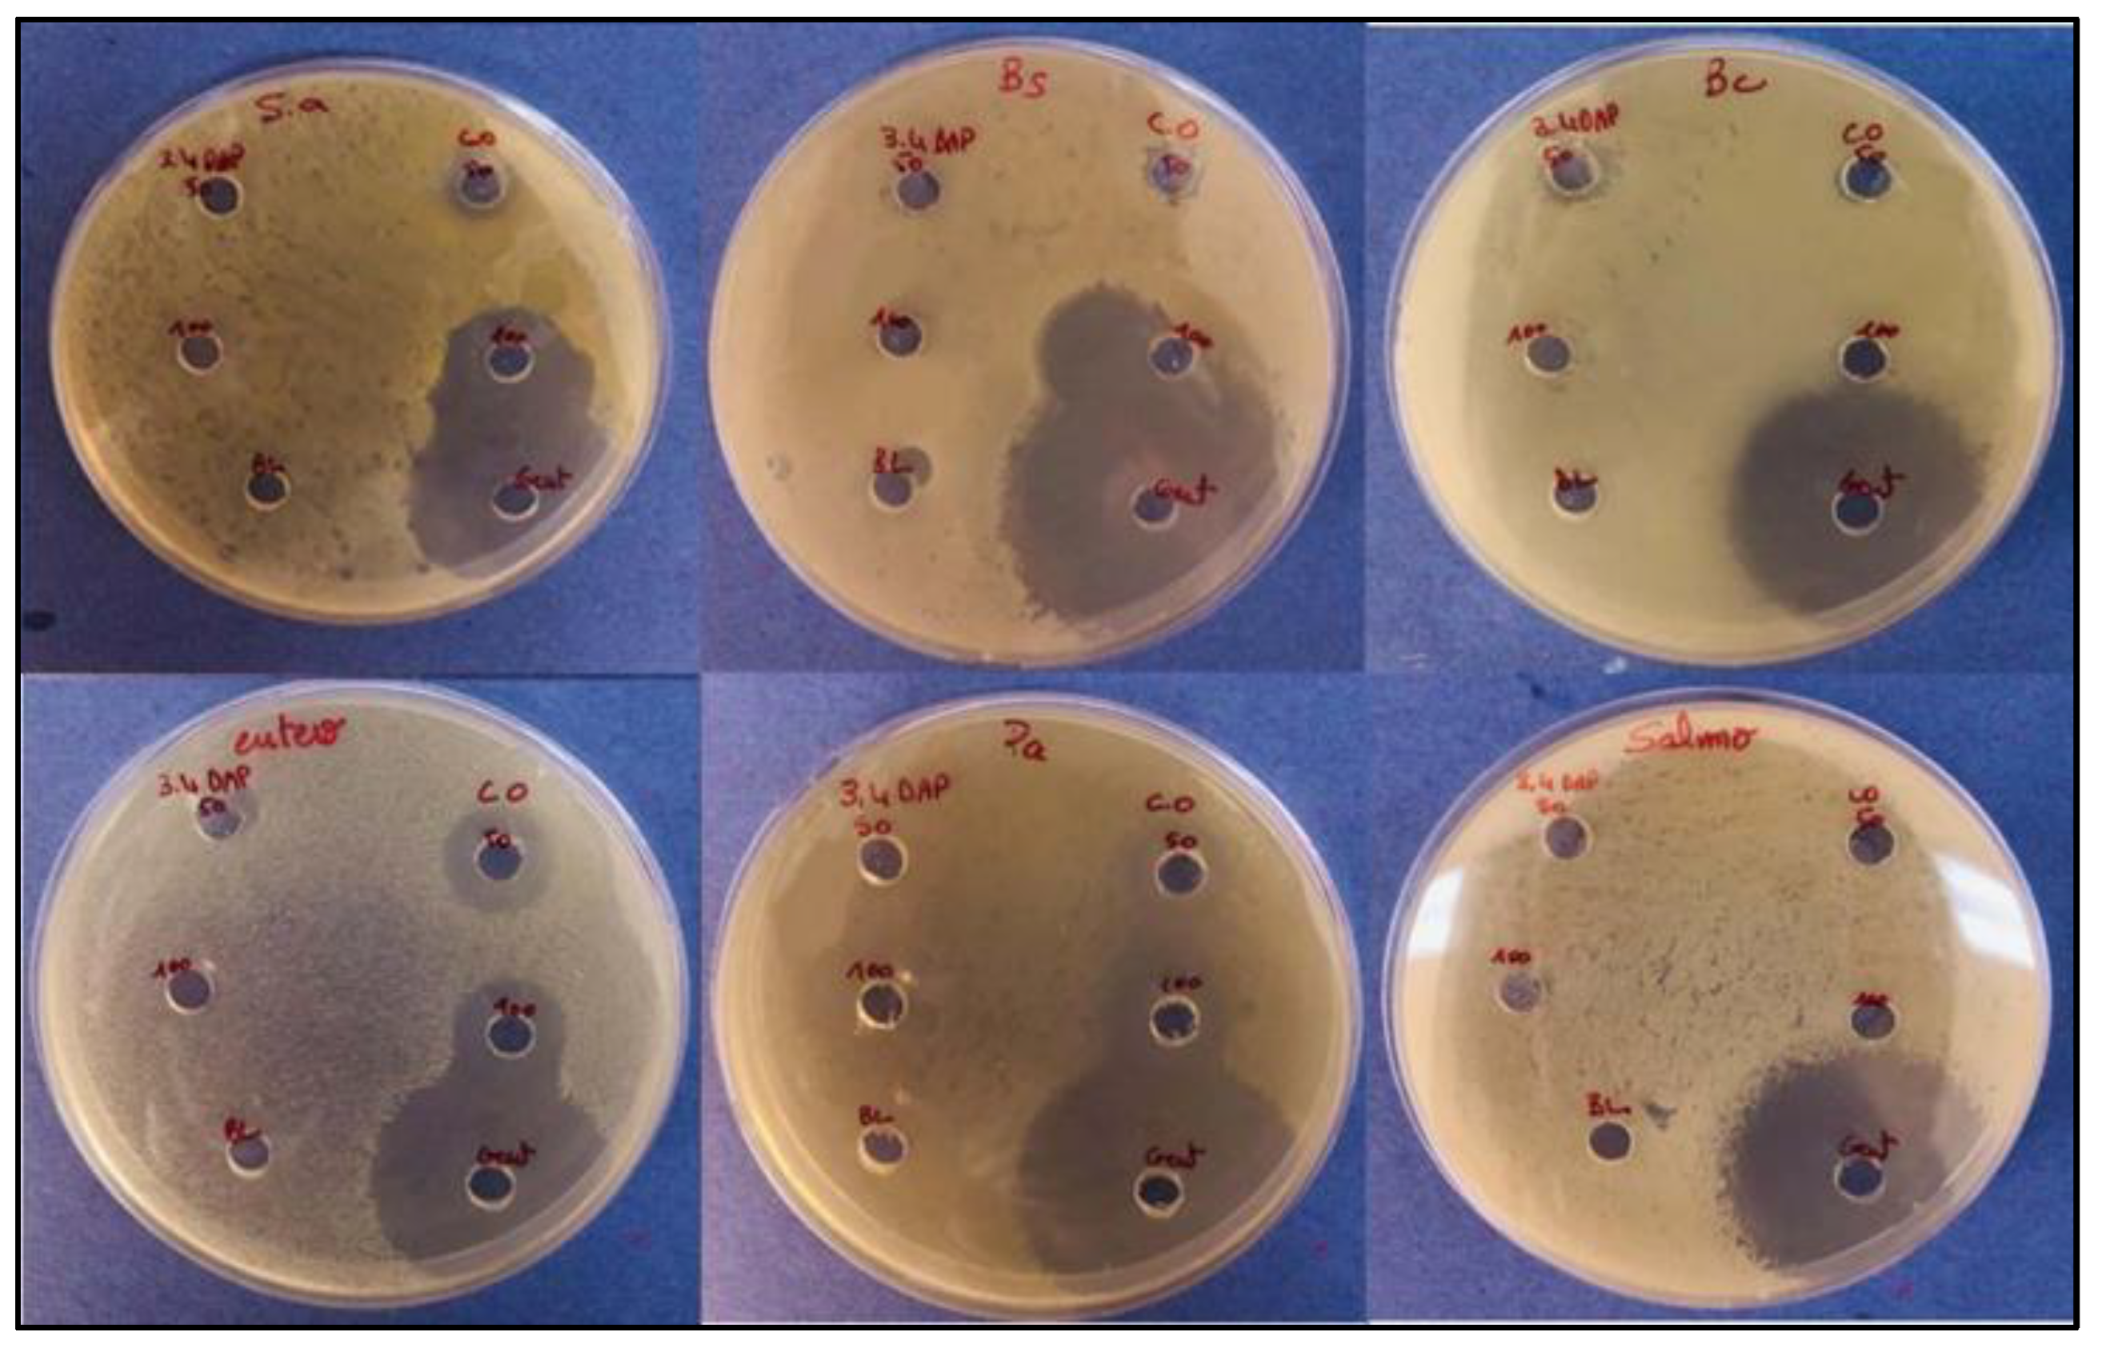

Submitted:
08 October 2024
Posted:
09 October 2024
You are already at the latest version
Abstract
Keywords:
1. Introduction
2. Materials and methods:
2.1. Synthesis

2.2. Spectroscopic Measurements
2.3. X-ray Data Collection and Structure Determination
2.4. Hirschfeld Surface Calculations
2.5. Thermal Analysis
2.6. Optical Study
2.7. Computational Details:
2.8. Determination of In-Vitro Antibacterial Activity by Agar Well Diffusion Method
3. Result and Discussion
3.1. Crystal Structures

3.2. Vibrational Spectroscopy Measurement:
3.3. Hirschfeld Surfaces and Crystal Voids
3.4. Thermal Analysis:
3.5. Optical Study:
3.6. DFT Analysis:
3.7. In-Vitro Antibacterial Results
4. Conclusions
Supplementary Materials
Accession Codes
References
- S. Sathiyakumar, P. Selvam, S. Antharjanam, F.L. Hakkim, K. Srinivasan, W.T.A. Harrison; Mechano-chemical syntheses of new cobalt (II) complexes ofalkyl 2- (pyridine-eyl-methylene) hydrazinecarboxylates: crystal structures, spectroscopic and photoluminescence properties;J. Mol. Struct. 1205 (2020) 127666, . [CrossRef]
- S.A. Zarei; A mononuclear cobalt(II) salophen-type complex: Synthesis, theoretical and experimental electronic absorption and infrared spectra, crystal structure, and predicting of second- and third-order nonlinear optical properties; J. Spectrochim, Acta A 215 (2019) 225, . [CrossRef]
- K. Kahouli, A.B. Kharrat, S. Chaabouni; Optical properties analysis of the new (C9H14N)3BiCl6 compound by UV–visible measurements; Indian J. Phys. 95 (2021) 2797, . [CrossRef]
- D. Pandiarajan, R. Rengan;Ruthenium (II) half-sandwich complexes containing thioamides: Synthesis, structures and catalytic transfer hydrogenation of ketones;J. Org. Chem 723 (2013) 26, . [CrossRef]
- W. Mao, J. Wang, X. Hu, B.Zhou, G. Zheng, S. Mo, S. Li, F. Long, Z. Zou; Synthesis, crystal structure, photoluminescence properties of organic-inorganic hybrid materials based on ethylenediamine bromide; J. Saudi Chemical Society 24 (2019) 52, . [CrossRef]
- Vakulka, E. Goreshnik, M. Jagodic, Z. Jaglicic, Z. Trontelj;Tetrahydrated bis(ethylenediamine)copper(II) sulfate: Crystal structure, Raman spectrum and magnetic susceptibility;J. Mol. Struct. 1210 (2020) 128002, . [CrossRef]
- J. Molgo, M. Lemeignan, F. Peradejordi;P.Lechat ;Presynaptic effects of aminopyridines on the neuromuscular junction of vertebrates ; J Pharmacology 16 (1985) 10, PMID: 2417060.
- G.E. Kirsch, T. Narahashi; 3,4-diaminopyridine. A potent new potassium channel blocker; J Biophys 22 (1978) 507, DOI: 10.1016/S0006-3495(78)85503-9.
- S.R. Schwid, M.D. Petrie, M.P. McDermott, D.S. Tierney, D.H. Maso, A.D. Goodman;Quantitative assessment of sustained-release 4-aminopyridine for symptomatic treatment of multiple sclerosis; J. Neurology 48 (1997) 817, . [CrossRef]
- K.M. McEvoy, A.J. Windebank, J.R. Daube, P.A. Low; 3,4-Diaminopyridine in the Treatment of Lambert–Eaton Myasthenic Syndrome; J. Med 321 (1989) 1567, DOI: 10.1056/NEJM198912073212303.
- M. Messaad, I. Dhouib, M. Abdelhedi, B. Khemakhem; Synthesis, bioassay and molecular docking of novel pyrazole and pyrazolone derivatives as acetylcholinesterase inhibitors; J. Mol. Struct. 1263 (2022) 133105, . [CrossRef]
- Carlsson, I. Rosen, E. Nilsson; Can 4-Aminopyridine be Used to Reverse Anaesthesia and Muscle Relaxation; J. Acta AnaesthesiolScand 27 (1993) 87, . [CrossRef]
- I. Bayar, L. Khedhiri, R. Fezai, P.S.P. da Silva, M.R. Silva, C. Nasr; A hybrid perchlorate with a low band gap: Crystal structure, physicochemical characterization and Hirschfeld surfaces study; J. Mol. Struct. 1181 (2019) 300, . [CrossRef]
- J. Janczak, G.J. Perpétuo; Supramolecular aggregation in new crystals with nonlinear optical properties: 2-aminophenol-HClO4, 3-aminophenol-HClO4 and 4-aminophenol-HClO4; J. Solid State Sciences 11 (2009) 1576, . [CrossRef]
- B.B. Koleva, T. Kolev, T. Tsanev, S. Kotov, H. Mayer-Figge, Rûdiger, W. Seidel, W.S. Sheldrick; Crystal structure, optical and magnetic properties of the bis(perchlorate) of 3,4-diaminopyridine; J. Struct. Chem. 19 (2008) 13, DOI 10.1007/s11224-007-9236-0.
- M.A. Spackman, P.G. Byrom ; A novel definition of a molecule in a crystal ; Chem. Phys. Lett. 267 (1997) 215, . [CrossRef]
- L.J. Farrugia;WinGX suite for small-molecule single-crystal crystallography; J. Appl. Crystallogr. 32 (1999) 837, . [CrossRef]
- G.M. Sheldrick, Crystal structure refinement with SHELXL; J. Acta Cryst. 71 (2015) 3, doi:10.1107/s2053229614024218.
- M.A. Spackman, D. Jayatilaka;Hirshfeld surface analysisJ.Cryst. Eng. Comm. 11 (2009) 19, DOI: 10.1039/B818330A.
- M.J. Frisch, G.W. Trucks, H.B. Schlegel, G.E. Scuseria, M.A. Robb, J.R. Cheeseman, G. Scalmani, V. Barone, B. Mennucci, G.A. Petersson, H. Nakatsuji, M. Caricato, X. Li, H.P. Hratchian, A.F. Izmaylov, J. Bloino, G. Zheng, J.L. Sonnenberg, M. Hada, M. Ehara, K. Toyota, R. Fukuda, J. Hasegawa, M. Ishida, T. Nakajima, Y. Honda, O. Kitao, H. Nakai, T. Vreven, J.A. Montgomery, Jr., J.E. Peralta, F. Ogliaro, 1 M. Bearpark, J.J. Heyd, E. Brothers, K.N. Kudin, V.N. Staroverov, R. Kobayashi, J. Normand, K. Raghavachari, A. Rendell, J.C. Burant, S.S. Iyengar, J. Tomasi, M. Cossi, N. Rega, J.M. Millam, M. Klene, J.E. Knox, J.B. Cross, V. Bakken, C. Adamo, J. Jaramillo, R. Gomperts, R.E. Stratmann, O. Yazyev, A.J. Austin, R. Cammi, C. Pomelli, J.W. Ochterski, R.L. Martin, K. Morokuma, V.G. Zakrzewski, G.A. Voth, P. Salvador, J.J. Dannenberg, S. Dapprich, A.D. Daniels, Ö. Farkas, J.B. Foresman, J.V. Ortiz, J. Cioslowski,, D.J. Fox, Gaussian 09, Gaussian, Inc., Wallingford CT (2009).
- A.R. Allouche, Gabedit is a free Graphical User Interface for computational chemistry packages; J. Computational Chem. 32 (2010) 174, . [CrossRef]
- L. Mary Novena, S. Suresh Kumar, S. Athimoolam; Improved solubility and bioactivity of theophylline (a bronchodilator drug) through its new nitrate salt analysed by experimental and theoretical approaches; J. Mol. Struct. 1116(2016) 45, . [CrossRef]
- N. Elleuch, D. Fredj, N. Chniba-Boudjada, M. Boujelbene; Synthesis of a New Chloro Antimony Complex with Pyridinium Derivative: Crystal Structure, Hirshfeld Surface Analysis, Vibrational, and Optical Properties; J. Inorg. and Organometallic Polymers and Materials 30 (2019) 889, . [CrossRef]
- J. Bernstein, R. E. Davis, L. Shimoni et N. -L. Chang; Patterns in Hydrogen Bonding: Functionality and Graph Set Analysis in Crystals; J. AngewandteChemie International Edition, 34 (1995) 1555, . [CrossRef]
- J. Zaleski and A. Pietraszko; Structure at 200 and 298 K and X-ray investigations of the phase transition at 242 K of [NH2(CH3)2]3Sb2Cl9 (DMACA); J. Acta Crystallogr. B 52 (1996) 287, . [CrossRef]
- Y.H. Luo, G.G. Wu, S. L Mao, B.W. Sun; Complexation of different metals with a novel N-donor bridging receptor and Hirshfeld surfaces analysis; J. InorgChim Acta 397 (2013) 1, . [CrossRef]
- M. J. Turner,J. J. McKinnon, , D. Jayatilaka,, Spackman ; M. A. ; Visualisation and characterisation of voids in crystalline materials;J. CrystEngComm, 13 (2011) 1804, . [CrossRef]
- E. Irrou, Y.A. Elmachkouri, A. Oubelle, H. Ouchtak, S. Dalbouha, J.T. Mague, T. Hökelek, L. El Ghayari, N.K. Sabber, and M.L. Taha; Crystal structure determination, Hirshfeld surface, crystal void, intermolecular interaction energy analyses, as well as DFT and energy framework calculations of 2-(4-oxo-4,5-dihydro-1H-pyrazolo- [3,4-d] pyrimidin-1-yl)acetic acid; J. Acta Cryst. E 78 (2022) 953, . [CrossRef]
- M. Kurbanova, M. Ashfaq, M. N. Tahir, A. Maharramov, N. Dege, N. Ramazanzade, E. B. Cinar; synthesis, crystal structure, supramolecular assembly inspection by hirshfeld surface analysis and computational exploration of 4-phenyl-6-(p-TOLYL) pyrimidin-2 (1H)-one (PPTP); J. Struct. Chem. 64 (2023) 437, DOI: 10.1134/S0022476623030095.
- B.B. Ivanova, M.G. Arnaudov, H. Mayer-Figge; Molecular spectral analysis and crystal structure of the 4-aminopyridinium tetrachloropalladate (II) complex salt; J. Polyhedron 24 (2005) 1624, . [CrossRef]
- I. Bayar, L. Khedhiri, F. Lefebvre, V. Ferretti, C.B. Nasr; Crystal structure, Hirshfeld surfaces computational study and physicochemical characterization of two new organic salts of 2-chlorobenzylamine, (ClC7H6NH3)·NO3 and (ClC7H6NH3)·ClO4; J. Mol. Struct. 1179 (2018) 171, . [CrossRef]
- K. Efil, Y. Bekdemir; Theoretical and experimental investigations on molecular structure, IR, NMR spectra and HOMO-LUMO analysis of4-methoxy-N-(3-phenylallylidene) aniline;Am. J. of Phy. Chem. 3 (2014), 19, doi: 10.11648/j.ajpc.20140302.13.
- I. Bayar, L. Khedhiri, E. Jeanneau, F. Lefebvre, C.Ben Nasr; Synthesis, structural study and characterization of two new (ClC7H6NH3)ClO4.H2O isostructural hydrates of isomeric organic amine perchlorates; J. Mol. Struct. 1211 (2020) 128078, . [CrossRef]
- L. Mary Novena, S. Suresh Kumar, S. Athimoolam; Improved solubility and bioactivity of theophylline (a bronchodilator drug) through its new nitrate salt analysed by experimental and theoretical approaches; J. Mol. Struct. 1116 (2016) 45, . [CrossRef]

| Crystallographic data | |
|---|---|
| Chemical formula | C5H8N3ClO4 |
| Color/form | Colorless / Prism |
| Formula weight (g/mol) | 209.59 |
| Cell volume Å3 | 403.2 (12) |
| Density (Mg m-3) | 1.726 |
| Crystal system | Monoclinic |
| Space group | P21 |
| Z | 2 |
|
Cell parameter a (Å) b (Å) c (Å) β (°) |
5.1261 (9) 9.3003 (17) 8.6659 (16) 102.595 (7) |
| Radiation of Mo | Monochromatique Kα |
| Diffractometer | APEX II, KAPPA CCD |
| Intensity collection condition | |
| Temperature (K) | 293 K |
| Wavelength (Å) | 0.71073 |
| Indexe range | -6<h<6 ; -10<k<10 ; -10<l<10 |
| Total number of recorded reflections | 19905 |
| Total number of independent reflections | 1361 |
| Domain of θ(°) | 2.4 < θ <24.7 |
| Structure determination and refinement | |
| reflexions with I>2σ (I) | 1327 |
| F(000) | 216 |
|
Refined parameters Flack parameter |
121 0.48 |
| Electronic density (e Å-3) | -0.43<Δρ< 0.33 |
| wR (F2) | 0.113 |
| R [F2> 2σ(F2)] | 0.041 |
|
S = GooF CCDC |
1.09 2300737 |
| Bacteria | Inhibition zone (mm) | |||||
|---|---|---|---|---|---|---|
| 3,4 DAPP | CO | ATB | C- | |||
| 50 | 100 | 50 | 100 | |||
| Staphylococcus aureus | - | - | 10 | 17 | 34 | 0 |
| Bacillus subtilis | - | - | 9 | 15 | 40 | 0 |
| Bacillus cereus | 10 | 0 | 7 | 0 | 35 | 0 |
| Enterococcus faecalis | 8 | - | 14 | 15 | 33 | 0 |
| Pseudomonas aeruginosa | - | - | 14 | 16 | 43 | 0 |
| Salmonella typhimurium | - | - | - | - | 32 | 0 |
Disclaimer/Publisher’s Note: The statements, opinions and data contained in all publications are solely those of the individual author(s) and contributor(s) and not of MDPI and/or the editor(s). MDPI and/or the editor(s) disclaim responsibility for any injury to people or property resulting from any ideas, methods, instructions or products referred to in the content. |
© 2024 by the authors. Licensee MDPI, Basel, Switzerland. This article is an open access article distributed under the terms and conditions of the Creative Commons Attribution (CC BY) license (http://creativecommons.org/licenses/by/4.0/).